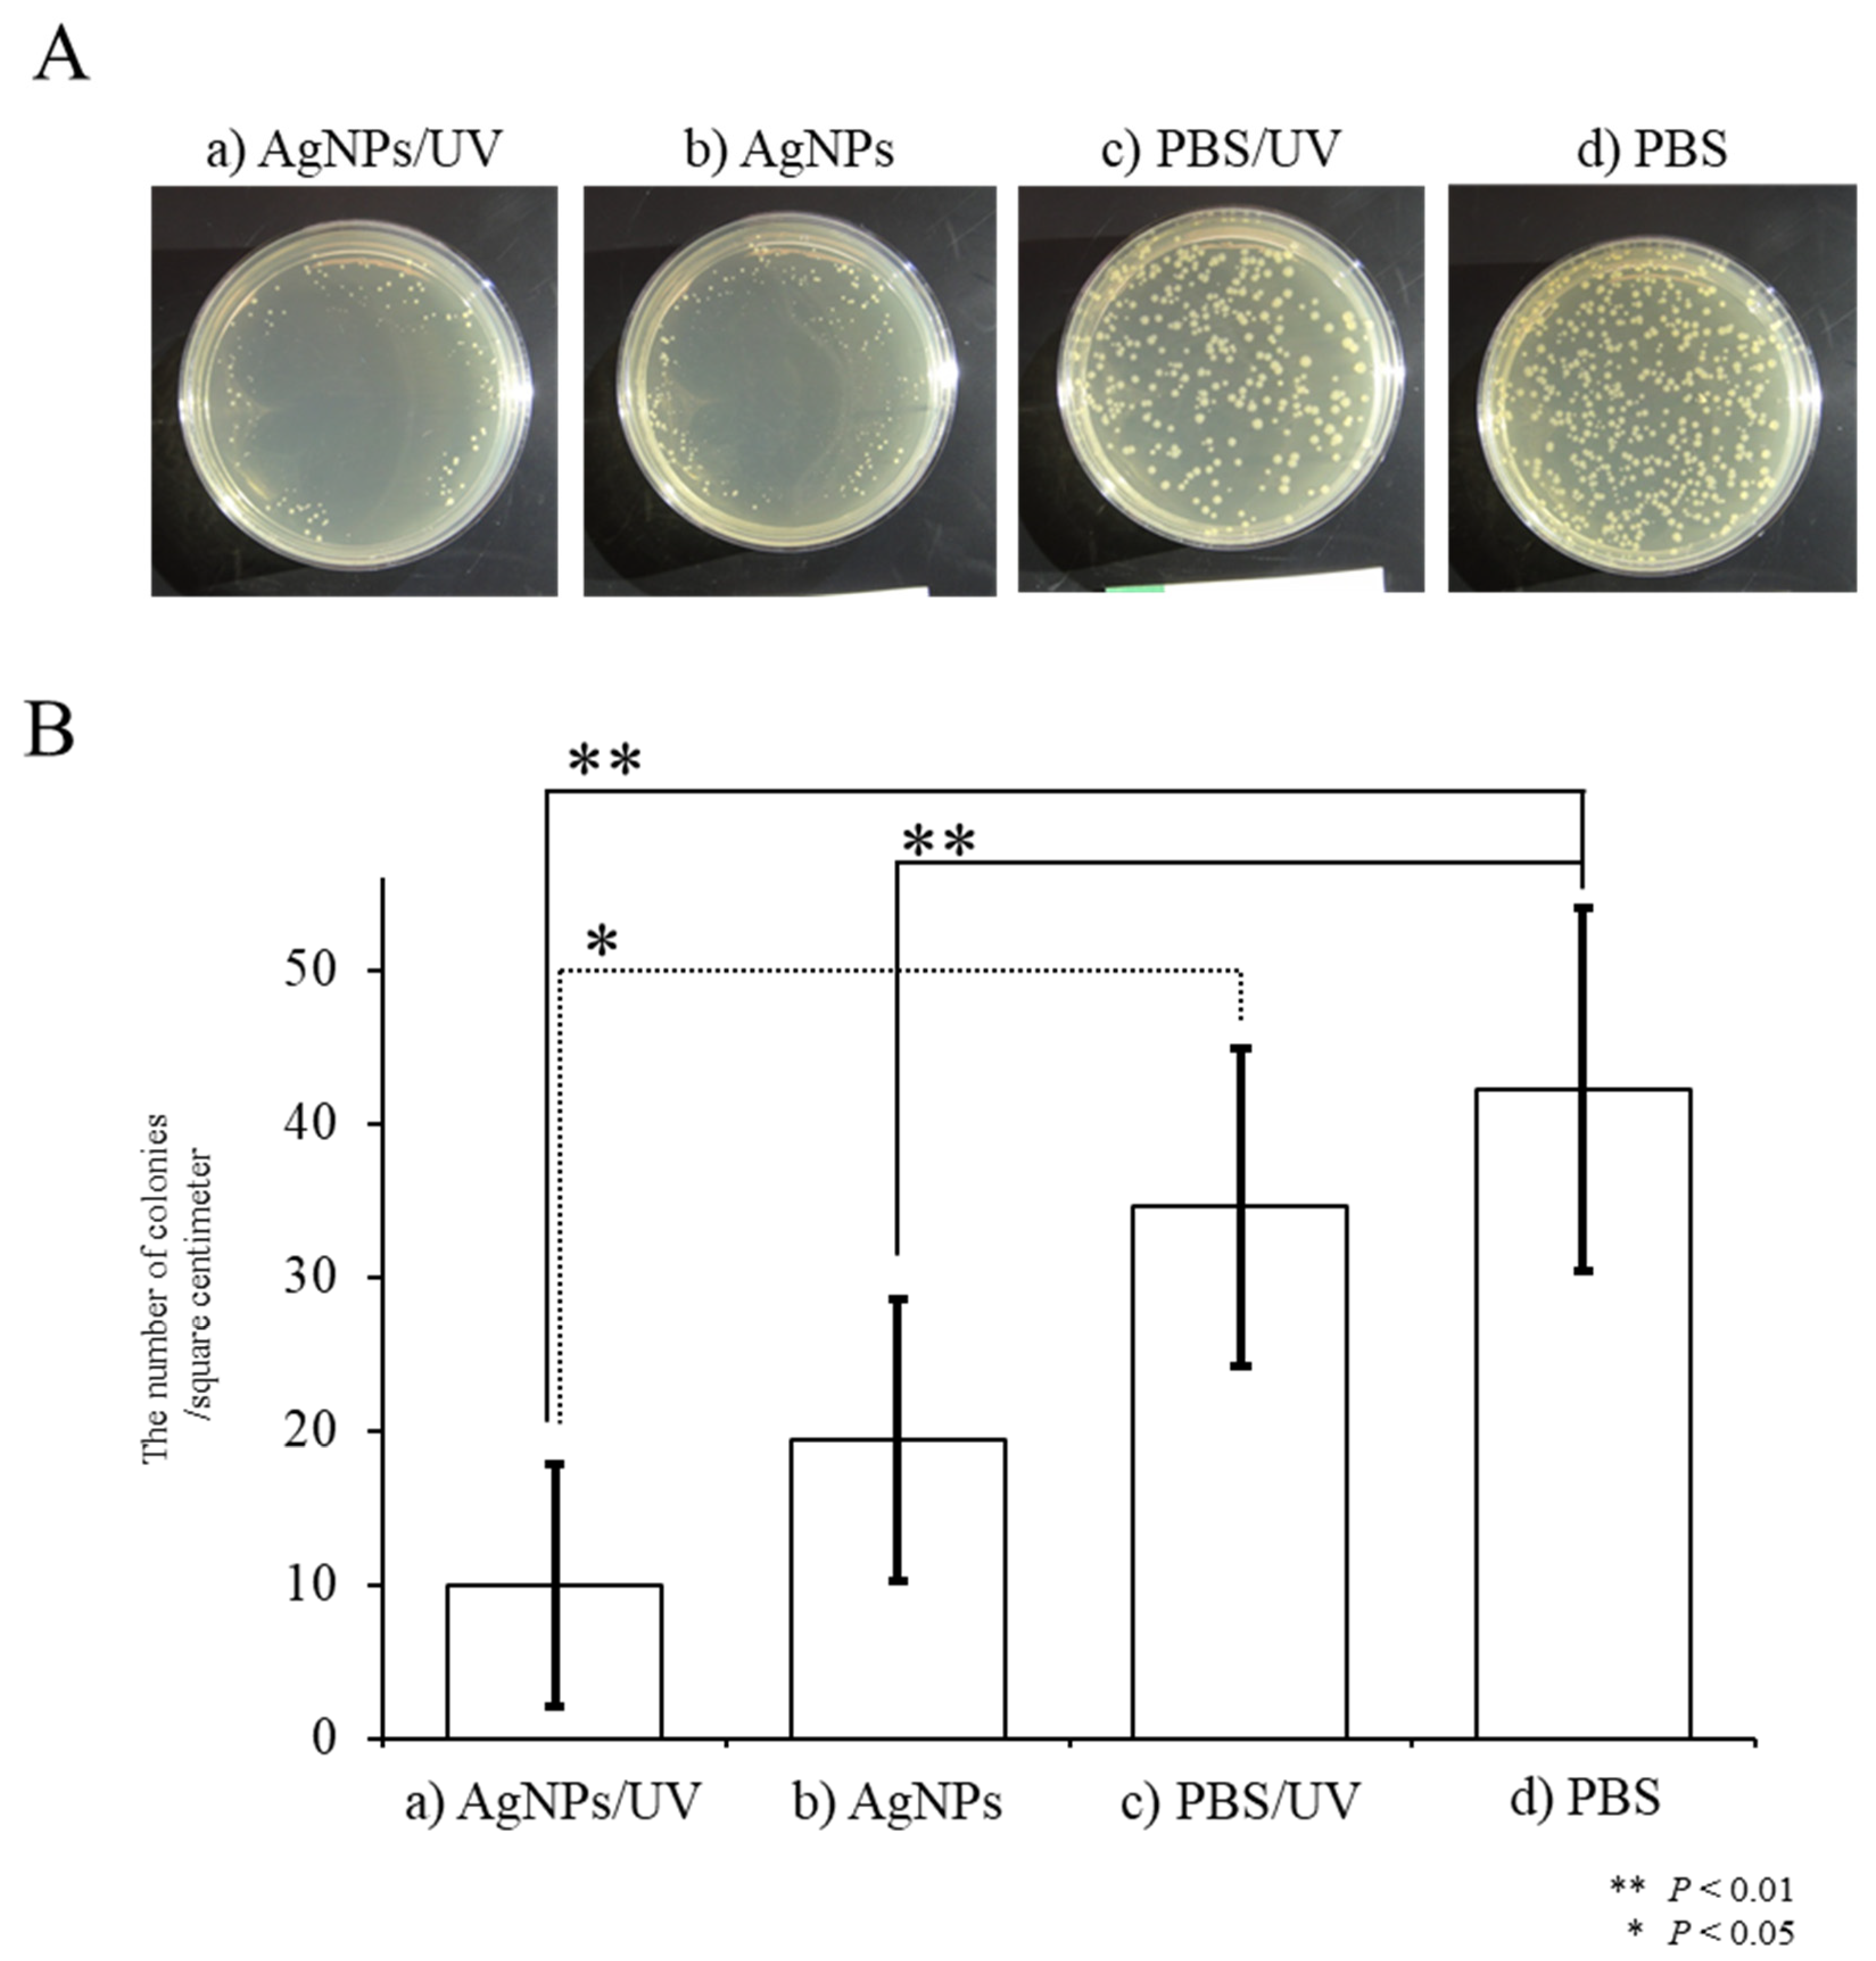
Ijms 21 03204 g004 Ijms 21 03204 g004

Ultraviolet Irradiation Enhances the Microbicidal Activity of Silver Nanoparticles by Hydroxyl Radicals
Abstract
1. Introduction
2. Results and Discussion
2.1. UV Irradiation-Induced Generation of Radicals
2.2. Antibacterial Activity of UV-Irradiated AgNPs
3. Materials and Methods
3.1. Preparation of AgNPs
3.2. Measurement of Radicals from UV-Irradiated AgNPs
3.3. Bactericidal Activity of UV-Irradiated AgNPs
3.4. Statistical Analysis
4. Conclusions
Author Contributions
Acknowledgments
Conflicts of Interest
Abbreviations
| AgNPs | silver nanoparticles |
| COVID-19 | coronavirus disease 2019 |
| DMPO | 5,5-dimethyl-1-pyrroline N-oxide |
| E. coli | Escherichia coli |
| EPR | electron paramagnetic resonance |
| HIV-1 | human immunodeficiency virus-1 |
| HSV | herpes simplex virus |
| MRSA | methicillin-resistant Staphylococcus aureus |
| NADH | nicotinamide adenine dinucleotide |
| PBS | Dulbecco’s modified phosphate-buffered saline without Ca2+ and Mg2+, pH 7.2 |
| ROS | reactive oxygen species |
| SARS | severe acute respiratory syndrome |
| SPR | surface plasmon resonance |
| UV | ultraviolet |
| UVA | ultraviolet A (320 to 400 nm) |
| UVB | ultraviolet B (280 to 320 nm) |
| UVC | ultraviolet C (200 to 280 nm) |
References
- Berger, T.J.; Spadaro, J.A.; Chapin, S.E.; Becker, R.O. Electrically generated silver ions: Quantitative effects on bacterial and mammalian cells. Antimicrob. Agents Chemother. 1976, 9, 357–358. [Google Scholar] [CrossRef] [PubMed]
- Ip, M.; Lui, S.L.; Poon, V.K.; Lung, I.; Burd, A. Antimicrobial activities of silver dressings: An in vitro comparison. J. Med. Microbiol. 2006, 55, 59–63. [Google Scholar] [CrossRef] [PubMed]
- Silvestry-Rodriguez, N.; Sicairos-Ruelas, E.E.; Gerba, C.P.; Bright, K.R. Silver as a disinfectant. Rev. Environ. Contam. Toxicol. 2007, 191, 23–45. [Google Scholar] [CrossRef] [PubMed]
- Alexander, J.W. History of the medical use of silver. Surg. Infect. 2009, 10, 289–292. [Google Scholar] [CrossRef]
- Liao, C.; Li, Y.; Tjong, S.C. Bactericidal and cytotoxic properties of silver nanoparticles. Int. J. Mol. Sci. 2019, 20, 449. [Google Scholar] [CrossRef] [PubMed]
- Marambio-Jones, C.; Hoek, E.M.V. A review of the antibacterial effects of silver nanomaterials and potential implications for human health and the environment. J. Nanopart. Res. 2010, 12, 1531–1551. [Google Scholar] [CrossRef]
- Chou, K.-S.; Lu, Y.-C.; Lee, H.-H. Effect of alkaline ion on the mechanism and kinetics of chemical reduction of silver. Mater. Chem. Phys. 2005, 94, 429–433. [Google Scholar] [CrossRef]
- Gong, P.; Li, H.; He, X.; Wang, K.; Hu, J.; Tan, W.; Zhang, S.; Yang, X. Preparation and antibacterial activity of Fe3O4@Ag nanoparticles. Nanotechnology 2007, 18, 285604. [Google Scholar] [CrossRef]
- Peiris, S.; McMurtrie, J.; Zhu, H.-Y. Metal nanoparticle photocatalysts: Emerging processes for green organic synthesis. Catal. Sci. Technol. 2016, 6, 320–338. [Google Scholar] [CrossRef]
- Sondi, I.; Salopek-Sondi, B. Silver nanoparticles as antimicrobial agent: A case study on E. coli as a model for Gram-negative bacteria. J. Colloid. Interface Sci. 2004, 275, 177–182. [Google Scholar] [CrossRef]
- Mehrbod, P.; Motamed, N.; Tabatabaian, M.; Soleimani Estyar, R.; Amini, E.; Shahidi, M.; Kheiri, M.T. In vitro antiviral effect of "nanosilver" on influenza virus. DARU J. Pharm. Sci. 2009, 17, 88–93. [Google Scholar]
- Devi, L.S.; Joshi, S.R. Antimicrobial and synergistic effects of silver nanoparticles synthesized using soil fungi of high altitudes of eastern himalaya. Mycobiology 2012, 40, 27–34. [Google Scholar] [CrossRef] [PubMed]
- Karmali, M.A. Factors in the emergence of serious human infections associated with highly pathogenic strains of shiga toxin-producing Escherichia coli. Int. J. Med. Microbiol. 2018, 308, 1067–1072. [Google Scholar] [CrossRef]
- Lara, H.H.; Ayala-Nuñez, N.V.; Ixtepan-Turrent, L.; Rodriguez-Padilla, C. Mode of antiviral action of silver nanoparticles against HIV-1. J. Nanobiotechnol. 2010, 8, 1. [Google Scholar] [CrossRef] [PubMed]
- Gaikwad, S.; Ingle, A.; Gade, A.; Rai, M.; Falanga, A.; Incoronato, N.; Russo, L.; Galdiero, S.; Galdiero, M. Antiviral activity of mycosynthesized silver nanoparticles against herpes simplex virus and human parainfluenza virus type 3. Int. J. Nanomed. 2013, 8, 4303–4314. [Google Scholar] [CrossRef]
- Nakamura, S.; Sato, M.; Sato, Y.; Ando, N.; Takayama, T.; Fujita, M.; Ishihara, M. Synthesis and application of silver nanoparticles (Ag NPs) for the prevention of infection in healthcare workers. Int. J. Mol. Sci. 2019, 20, 3620. [Google Scholar] [CrossRef]
- Nguyen, V.Q.; Ishihara, M.; Mori, Y.; Nakamura, S.; Kishimoto, S.; Fujita, M.; Hattori, H.; Kanatani, Y.; Ono, T.; Miyahira, Y.; et al. Preparation of size-controlled silver nanoparticles and chitosan-based composites and their anti-microbial activities. Biomed. Mater. Eng. 2013, 23, 473–483. [Google Scholar] [CrossRef]
- Nguyen, V.Q.; Ishihara, M.; Kinoda, J.; Hattori, H.; Nakamura, S.; Ono, T.; Miyahira, Y.; Matsui, T. Development of antimicrobial biomaterials produced from chitin-nanofiber sheet/silver nanoparticle composites. J. Nanobiotechnol. 2014, 12, 49. [Google Scholar] [CrossRef]
- Ishihara, M.; Nguyen, V.Q.; Mori, Y.; Nakamura, S.; Hattori, H. Adsorption of silver nanoparticles onto different surface structures of chitin/chitosan and correlations with antimicrobial activities. Int. J. Mol. Sci. 2015, 16, 13973–13988. [Google Scholar] [CrossRef]
- Mori, Y.; Tagawa, T.; Fujita, M.; Kuno, T.; Suzuki, S.; Matsui, T.; Ishihara, M. Simple and environmentally friendly preparation and size control of silver nanoparticles using an inhomogeneous system with silver-containing glass powder. J. Nanopart. Res. 2011, 13, 2799–2806. [Google Scholar] [CrossRef]
- Mori, Y.; Ono, T.; Miyahira, Y.; Nguyen, V.Q.; Matsui, T.; Ishihara, M. Antiviral activity of silver nanoparticle/chitosan composites against H1N1 influenza A virus. Nanoscale Res. Lett. 2013, 8, 93. [Google Scholar] [CrossRef] [PubMed]
- Kinoda, J.; Ishihara, M.; Hattori, H.; Nakamura, S.; Fukuda, K.; Yokoe, H. Cytotoxicity of silver nanoparticle and chitin-nanofiber sheet composites caused by oxidative stress. Nanomaterials 2016, 6, 189. [Google Scholar] [CrossRef] [PubMed]
- Jayasmita, J.; Mainak, G.; Tarasankar, P. Enlightening surface plasmon resonance effect of metal nanoparticles for practical spectroscopic application. RSC Adv. 2016, 89, 86174–86211. [Google Scholar] [CrossRef]
- Nguyen, V.Q.; Ishihara, M.; Nakamura, S.; Hattori, H.; Ono, T.; Miyahira, Y.; Matsui, T. Interaction of silver nanoparticles and chitin powder with different sizes and surface structures: The correlation with antimicrobial activities. J. Nanomater. 2013, 2013, 1–9. [Google Scholar] [CrossRef]
- Hollosy, F. Effects of ultraviolet radiation on plant cells. Micron (Oxford, England: 1993) 2002, 33, 179–197. [Google Scholar] [CrossRef]
- Surjadinata, B.B.; Jacobo-Velazquez, D.A.; Cisneros-Zevallos, L. UVA, UVB and UVC light enhances the biosynthesis of phenolic antioxidants in fresh-cut carrot through a synergistic effect with wounding. Molecules 2017, 22, 668. [Google Scholar] [CrossRef]
- Zhang, L.; Wu, L.; Si, Y.; Shu, K. Size-dependent cytotoxicity of silver nanoparticles to Azotobacter vinelandii: Growth inhibition, cell injury, oxidative stress and internalization. PLoS ONE 2018, 13, e0209020. [Google Scholar] [CrossRef]
- Quinteros, M.A.; Cano Aristizabal, V.; Dalmasso, P.R.; Paraje, M.G.; Paez, P.L. Oxidative stress generation of silver nanoparticles in three bacterial genera and its relationship with the antimicrobial activity. Toxicol. In Vitro 2016, 36, 216–223. [Google Scholar] [CrossRef]
- Dabrowska-Bouta, B.; Sulkowski, G.; Struzynski, W.; Struzynska, L. Prolonged exposure to silver nanoparticles results in oxidative stress in cerebral myelin. Neurotox. Res. 2019, 35, 495–504. [Google Scholar] [CrossRef]
- Gasmalla, H.B.; Lu, X.; Shinger, M.I.; Ni, L.; Chishti, A.N.; Diao, G. Novel magnetically separable of Fe3O4/Ag3PO4@WO3 nanocomposites for enhanced photocatalytic and antibacterial activity against Staphylococcus aureus (S. aureus). J. Nanobiotechnol. 2019, 17, 58. [Google Scholar] [CrossRef]
- Lee, B.; Lee, M.J.; Yun, S.J.; Kim, K.; Choi, I.H.; Park, S. Silver nanoparticles induce reactive oxygen species-mediated cell cycle delay and synergistic cytotoxicity with 3-bromopyruvate in Candida albicans, but not in Saccharomyces cerevisiae. Int. J. Nanomed. 2019, 14, 4801–4816. [Google Scholar] [CrossRef] [PubMed]
- Li, M.; Yin, J.J.; Wamer, W.G.; Lo, Y.M. Mechanistic characterization of titanium dioxide nanoparticle-induced toxicity using electron spin resonance. J. Food. Drug Anal. 2014, 22, 76–85. [Google Scholar] [CrossRef] [PubMed]
- Oliveira, E.; Santos, H.M.; Garcia-Pardo, J.; Diniz, M.; Lorenzo, J.; Rodríguez-González, B.; Capelo, J.L.; Lodeiro, C. Synthesis of functionalized fluorescent silver nanoparticles and their toxicological effect in aquatic environments (Goldfish) and HEPG2 cells. Front. Chem. 2013, 1, 29. [Google Scholar] [CrossRef] [PubMed]

© 2020 by the authors. Licensee MDPI, Basel, Switzerland. This article is an open access article distributed under the terms and conditions of the Creative Commons Attribution (CC BY) license (http://creativecommons.org/licenses/by/4.0/).
Share and Cite
Nakamura, S.; Ando, N.; Sato, M.; Ishihara, M. Ultraviolet Irradiation Enhances the Microbicidal Activity of Silver Nanoparticles by Hydroxyl Radicals. Int. J. Mol. Sci. 2020, 21, 3204. https://doi.org/10.3390/ijms21093204
Nakamura S, Ando N, Sato M, Ishihara M. Ultraviolet Irradiation Enhances the Microbicidal Activity of Silver Nanoparticles by Hydroxyl Radicals. International Journal of Molecular Sciences. 2020; 21(9):3204. https://doi.org/10.3390/ijms21093204
Chicago/Turabian StyleNakamura, Shingo, Naoko Ando, Masahiro Sato, and Masayuki Ishihara. 2020. "Ultraviolet Irradiation Enhances the Microbicidal Activity of Silver Nanoparticles by Hydroxyl Radicals" International Journal of Molecular Sciences 21, no. 9: 3204. https://doi.org/10.3390/ijms21093204
APA StyleNakamura, S., Ando, N., Sato, M., & Ishihara, M. (2020). Ultraviolet Irradiation Enhances the Microbicidal Activity of Silver Nanoparticles by Hydroxyl Radicals. International Journal of Molecular Sciences, 21(9), 3204. https://doi.org/10.3390/ijms21093204

